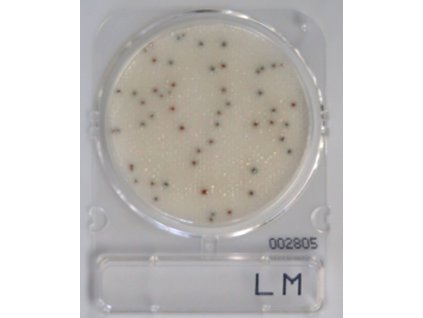
Compact Dry LM

Novinky
1 900 Kč
3 990 Kč
2 900 Kč
Akční zboží
Původně: 618 Kč
(–20 %)
490 Kč
Původně: 638 Kč
(–24 %)
480 Kč
Původně: 946 Kč
(–30 %)
660 Kč
Původně: 176 Kč
(–15 %)
149 Kč
Vítáme Vás v eshopu společnosti QUALIFOOD s.r.o. Všechny produkty pro Vás pečlivě vybíráme u prověřených dodavatelů s kterými dlouhodobě spolupracujeme.
Prezenční a online kurzy včetně kurzů IFS Academy naleznete na samostatné stránce www.QUALIFOODAcademy.cz.
QUALIFOOD s.r.o. je jako zástupce IFS Management GmbH pro Českou republiku a Slovensko organizátorem IFS konference o bezpečnosti potravin.